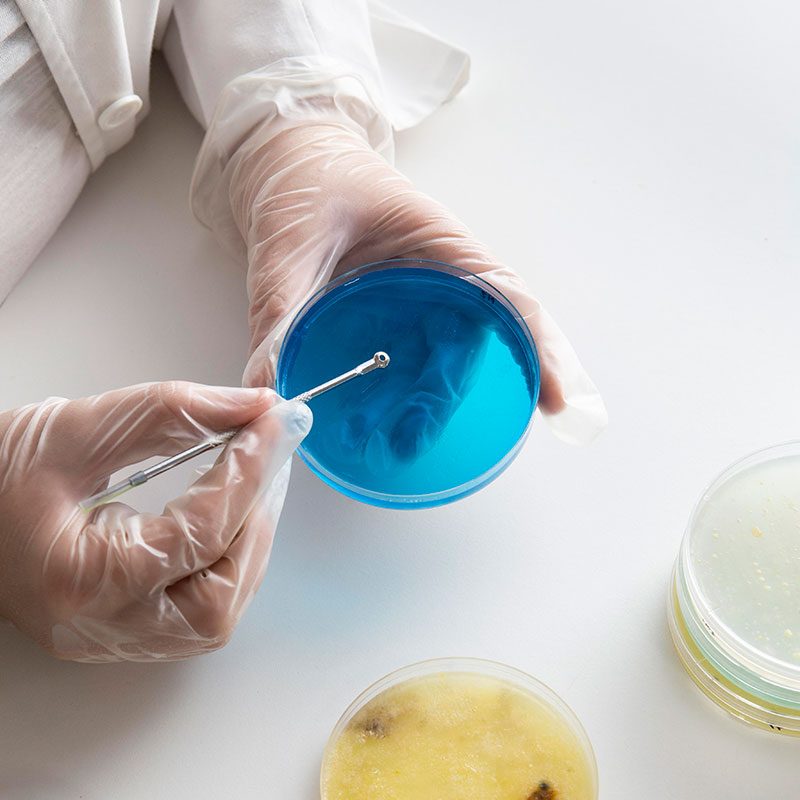
Probiotic Research

Understanding Probiotics
Probiotics are live beneficial bacteria that help maintain a healthy gut microbiome and support digestion and immunity.
The human gut is home to a complex ecosystem that plays a critical role in overall health, from nutrient absorption to immune regulation and even mental well-being.
- Over 100 trillion microorganisms reside in the gut
- 80% of the immune system is linked to gut health
- Gut-brain axis influences mood and cognition
- Balanced microbiome is essential for overall wellness
100T+
Gut Microorganisms
80%
Immunity from Gut